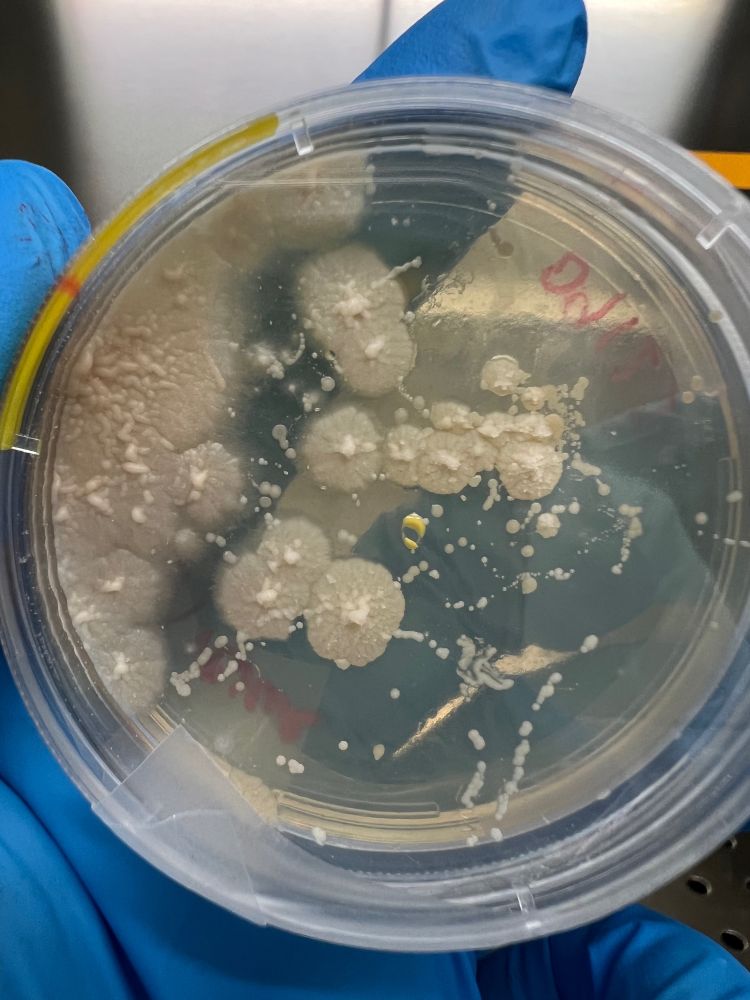

We invite you to submit your abstracts to our session ‘Understanding the roles of Endozoicomonadaceae in coral reef holobionts: Mutualists, parasites, and everything in between?’ at the next International Coral Reef Symposium
from July 19–24, 2026 in Auckland.


We invite you to submit your abstracts to our session ‘Understanding the roles of Endozoicomonadaceae in coral reef holobionts: Mutualists, parasites, and everything in between?’ at the next International Coral Reef Symposium
from July 19–24, 2026 in Auckland.

Job offer below. Pls share!
🪸🧫🧬



Job offer below. Pls share!
🪸🧫🧬

Further details:
www.campusfrance.org/en/mopga-2024
and below:

Further details:
www.campusfrance.org/en/mopga-2024
and below: